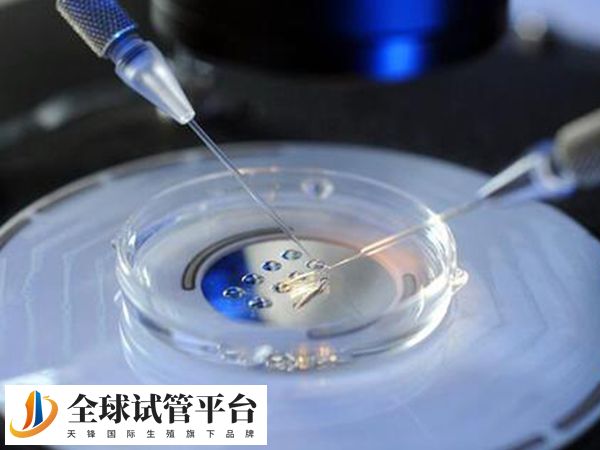
全国首批开展试管的医院是北医三院

北京大学第三医院和第一医院并没有哪个更好的说法,在试管方面选择北医三院会更好一些,因为两者的区别还是很大的。其中北京大学第三医院具有更为显著的优势和经验,尤其是在生殖医学技术和历史成就方面。毕竟该院是中国试管婴儿的发源地,具有丰富的试管婴儿操作经验。不仅如此,还拥有先进的辅助生殖技术和设备,是国内首批生殖医学临床培训基地;而北京大学第一医院虽然没有直接的信息表明其在试管婴儿方面的具体成就,但作为一家大型综合医院,其在生殖医学领域也可能具备相应的设施和专家团队。

做试管北京大学第三医院和第一医院哪个好
根据相关了解,不孕不育症夫妇做试管婴儿选择北京大学第三医院相比第一医院会更好一些,因为北医三院试管婴儿成功率更高,经验也更丰富,针对不清楚具体情况的患者,可以参考以下区别:
医院概况和特色
北京大学第三医院(北医三院)建立于1958年,是国家卫生健康委委管的综合性三甲医院,以医疗、教学、科研、预防保健、康复与健康管理为一体。北医三院在多个领域展现出其优势,如脊柱外科、生殖医学、运动医学、眼科和消化科等。

北京大学第一医院始建于1915年,是中国最早的国立医院之一,也是中央保健基地医院。北大医院在肾脏内科、泌尿外科、皮肤科、儿科、风湿免疫科、感染疾病科和心血管内科等领域具有显著优势。
专业特长
北京大学第三医院该医院的生殖医学中心是国内首批开展辅助生殖技术的科室之一,拥有经验丰富的专家团队,擅长处理各类复杂的不孕不育病症,尤其是在高龄女性助孕和反复种植失败等疑难问题上有深入的研究和实践;北京大学第一医院虽然具体特长没有详细说明,但作为一家综合性医院,其生殖医学中心也可能在试管婴儿技术方面具有相应的实力和经验。
地理位置和便利性
北京大学第三医院位于北京市,地理位置优越,交通便利,便于患者前往;北京大学第一医院同样位于北京市,地理位置也相当便利,便于患者访问。
科研与教学
北医三院参与多项国家级科研项目,并拥有多个国家临床重点专科。北京大学第一医院作为老资格的医院,北大医院在临床科学研究和教学方面也有深厚的底蕴,是多个医学会的副主任委员单位。






